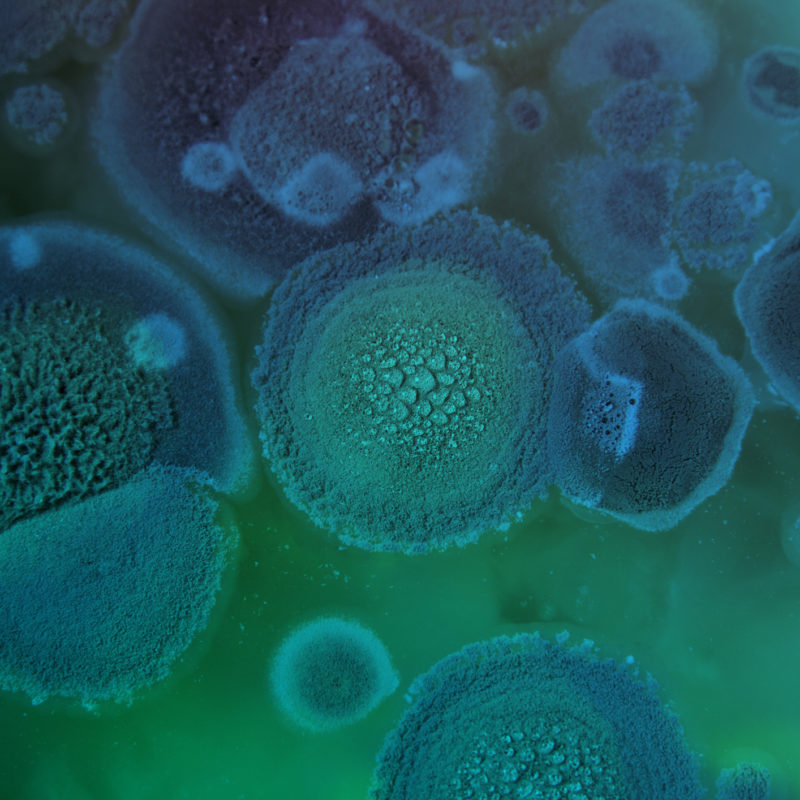

Recent News
-
 How to Wash Your E-Bike November 7, 2025
How to Wash Your E-Bike November 7, 2025 -
 How to Clean Microfiber Cloths September 22, 2025
How to Clean Microfiber Cloths September 22, 2025 -
 UV Protection for Your Car’s Paint August 7, 2025
UV Protection for Your Car’s Paint August 7, 2025 -
 How to Clean Fabric Car Seats: Removing Stains and Deep Cleaning Your Car’s Interior August 5, 2025
How to Clean Fabric Car Seats: Removing Stains and Deep Cleaning Your Car’s Interior August 5, 2025 -
 Everything You Need to Know about Ceramic Coatings July 8, 2025
Everything You Need to Know about Ceramic Coatings July 8, 2025
What’s Trending
Featured Products
-
 Ceramic GWash
Rated 5.00 out of 5From: $25.95
Ceramic GWash
Rated 5.00 out of 5From: $25.95 -
 Detailing Bucket Kit
$39.95
Detailing Bucket Kit
$39.95
-
 Marine Microfibre Wash Mitt
$18.95
Marine Microfibre Wash Mitt
$18.95